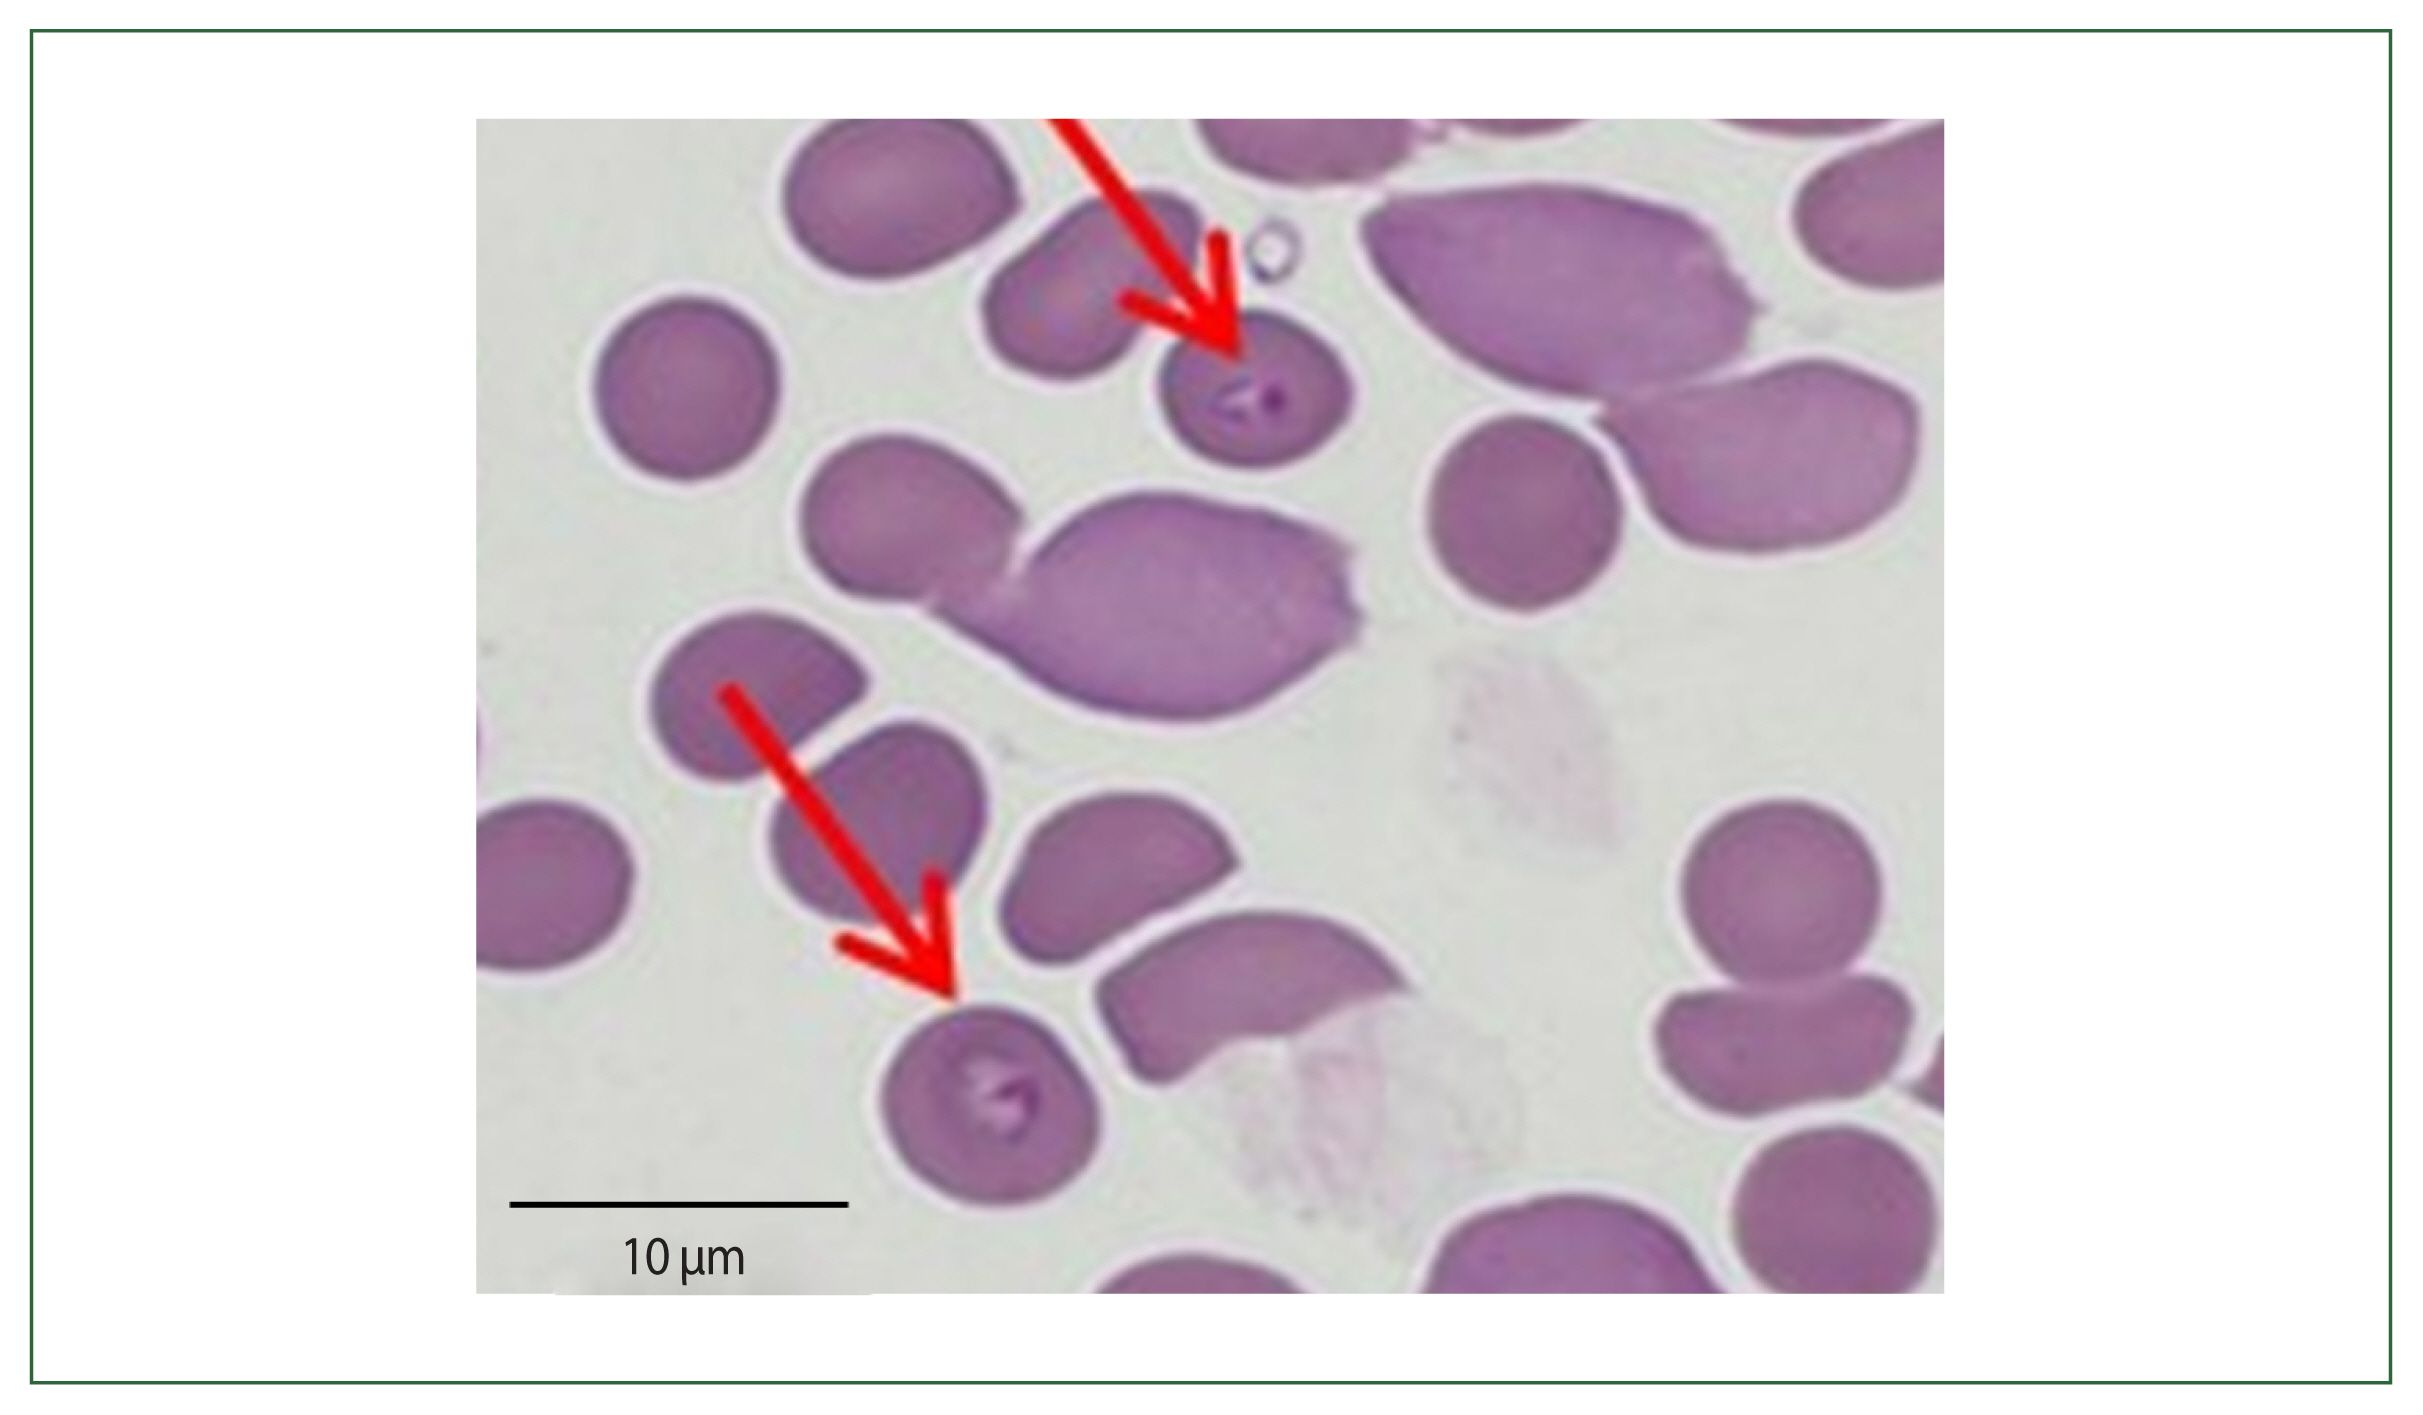
1

Abstract
Human babesiosis is a tick-borne disease induced by the genus Babesia and has been significantly reported in the Republic of Korea. This report shows the cases of 2 patients with human babesiosis who traveled to the USA in 2019. The 2 patients experienced fever and had travel histories to babesiosis-endemic regions. The diagnoses of both cases were verified by the identification of Babesia-infected red blood cells on blood smears. One patient was found to be infected with Babesia microti using polymerase chain reaction (PCR) for 18S rRNA, which discovered the phylogenetic link to the B. microti strain endemic in the USA. The 2 patients recovered from fever with subsequent hemoparasite clearance. Babesiosis could be diagnosed in anyone with histories of travel to babesiosis-endemic countries and tick bites. Furthermore, Babesia-specific PCR is required for determining geno-and phenotypic characteristics.
-
Key words: Babesia, Babesia microti, human babesiosis, imported case
Introduction
Babesiosis is a worldwide emerging tick-borne disease from an infection induced by the genus
Babesia, which is transmitted by ixodid ticks. More than 100 species of
Babesia can infect different domestic and wild animals [
1], but only a few species infect humans [
2,
3], including
B. microti, B. divergens, B. duncani, B. venatorum, B. crassa-like agents,
Babesia sp. MO1, and
B. motasi-like agents. The majority of human babesiosis cases in the USA are induced by
B. microti, which causes about 1,500 cases per year. It is endemic to the northeastern and midwestern regions of the USA, and babesiosis occurrences have risen and expanded geographically between 2011 and 2015 [
3].
Clinical symptoms of babesiosis range from asymptomatic to fulminant. The most typical symptoms of human babesiosis include fever, fatigue, chills, headache, and myalgia. Babesiosis has malaria-like symptoms [
4], requiring a differential diagnosis from malaria. Babesiosis diagnoses can be verified by the identification of intraerythrocytic parasites on a blood smear or confirmation of
Babesia DNA using polymerase chain reaction (PCR) [
5].
Since the initial report of human babesiosis in the Republic of Korea in 1988 [
6], 14 additional cases of babesiosis have been revealed. Most of these cases were imported [
7,
8], and only 2 were known to be locally transmitted, which were infected with
Babesia sp. KO-1 and
B. motasi-like agents [
9,
10].
This research reports 2 patients with a travel history to babesiosis-endemic regions of the USA. Blood smears and/or PCR tests found the Babesia pathogen.
Case Records
Case 1
A 56-year-old man was hospitalized in July 2019 due to fever, fatigue, and general malaise at the Seoul Samsung Medical Center, Seoul, Korea. The patient had traveled to the USA from July 3 to 7, 2019, and did not remember having any tick or insect bites. The patient was first diagnosed with babesiosis according to the microscopic outcome of Babesia sp. on a Giemsa-stained blood smear and a confirmed travel history to endemic regions of the USA. To determine the presence of Babesia sp., and rule-out Plasmodium infection, the blood smear slides were transferred to the Korea Disease Control Agency (KDCA).
Blood smear analysis discovered the presence of intraerythrocytic parasites (
Fig. 1). Tetrads or Maltese cross forms (which do not occur in
Plasmodium infections) of
Babesia sp. were found on thin blood films. Ring and trophozoite-like forms were also found in the blood smears. The patient had 2.5% parasitemia. Additionally, DNA was extracted from the blood smear slide and assayed by PCR to determine and amplify
Babesia and
Plasmodium-specific genes. However, PCR-amplified products were not found. Following their diagnosis, the patient had atovaquone, and azithromycin for babesiosis and recovered uneventfully.
A 67-year-old woman was admitted for fever and chills at Asan Medical Center, Seoul, Korea on July 22, 2019. The fever began 4 days before admission and general weakness and anorexia accompanied. A complete blood count revealed anemia and thrombocytopenia with the patient having a hemoglobin level of 8.1 g/L and a platelet count of 50,000/mm3. Serum lactate dehydrogenase level and c-reactive protein levels were risen at 771 and 7.9 mg/dl, respectively. Computed tomography scans of the chest and abdomen were conducted and discovered an enlarged spleen of 13 cm at the largest diameter. The peripheral blood smear demonstrated the trophozoite form of protozoa resembling Plasmodum species inside the red blood cells. However, a quick diagnostic test for malaria (Carestart) indicated negative results for both P. falciparum and P. vivax. The patient’s travel history and potential exposure to mosquitos and ticks were comprehensively reviewed.
The patient had visited her daughter’s house at Weston near Boston, Massachusetts, USA. She stayed 1 month (May 19 to June 19) in her daughter’s home and came back to Korea 1 month before her admission. Her daughter’s house had a spacious garden with a pond inside. The patient recalled cleaning the pond and receiving multiple insect bites. According to the travel history, peripheral blood smear outcomes, and negative rapid test for malaria, babesiosis was highly suspected (
Fig. 2). More focused microscopic examinations showed extracellular ring form protozoa and typical tetrad-form merozoites, further indicating a
Babesia infection. The patient’s blood sample was transferred to KDCA for systematic diagnosis on July 25, 2019.
The patient’s parasitemia level was 2%. To determine
Babesia sp., the 18S rRNA gene was amplified via a nested PCR test of the blood. The first PCR was conducted using the primers BTH-F (5′-CCTGAGAAACGGCTACCACATCT-3′) and BTH-R (5′-TTGCGACCATACTCCCCCCA-3′), and the second PCR was conducted using GF2F (5′-GTCTTGTAATTGGAATGATG-3′) and GR2R (5′-CCAAAGACTTTGATTTCTCTC-3′). A 588 base-pair amplicon was acquired, computed in the NCBI database, and determined as a
Babesia strain resembling the type prevalently found in the USA (
Fig. 3).
B. microti serologic tests were carried out using indirect immunofluorescence antibody testing to distinguish between antibodies and
Babesia species. The antibody titer for
B. microti was considerably higher (1:64) (data not displayed). Atovaquone and azithromycin were given, after which the patient’s symptoms generally enhanced.
Discussion
The prevalence rates and geographic occurrence of human babesiosis have been rising globally. In the USA, human babesiosis is prevalently induced by
B. microti and occasionally by
Babesia WA1. In Europe, most cases were found in France and Ireland and were induced by
B. divergens [
3,
4]. In Asia, multiple species of
Babesia have been discovered in China and the Republic of Korea, including
B. venatorum (China),
Babesia sp. KO-1, and
B. motasi-like agent (Republic of Korea) [
9–
11]. Human babesiosis is induced by the asexual reproduction of
Babesia parasites in host erythrocytes, causing red blood cell hemolysis [
12]. Consequently, several clinical manifestations reflective of the parasitemia level are revealed. The incubation period of babesiosis is typically 1–6 weeks after a tick bite, depending on the host’s general condition and the infecting
Babesia strain [
4]. Confirmation of particular tick bites for both of our patients could not be identified. However, considering that both patients had recently visited babesiosis-endemic regions of the USA and their clinical symptoms aligned with those commonly presenting within the general babesiosis incubation period, a diagnosis of babesiosis was identified.
Morphologically,
Babesia species commonly appear as round-, oval-, or pear-shaped within red blood cells. The ring form is the most prevalent morphological characteristic of
Babesia, which can be misconstrued with the features of
P. falciparum. The tetrad form (called “Maltese cross”) is the pathognomonic form for babesiosis but is rarely found.
Babesia was historically classified by the morphology of the intraerythrocytic forms, which can be divided into small (trophozoite measurement: 1–2.5 μm; included species:
B. microti,
B. gibsoni, and
B. rodhaini) and large (trophozoite measurement: 2.5–5.0 μm; included species:
B. bovis, B. caballi, and
B. canis)
Babesia [
1,
13]. In the first case of our research, we found tetrads of
Babesia sp., which are a feature of babesiosis, prompting the babesiosis diagnosis. However, in the second case, only ring forms were found in blood smears, which were confusing to differentiate from
P. falciparum. There is limited accuracy in depending on these morphological characteristics as comparable or identical species can not be distinguished [
14]. Morphological classification methods are gradually being supplanted by more recent molecular biological methods, which are more helpful in differentiating between related species and verifying distinctions based on subjective characteristics.
On a species-level classification, recent molecular studies demonstrated that the
B. microti group is a complex species involving 4 groups, including the US, Munich, Kobe, and Hobetsu types [
1,
15]. Under the
B. microti group, the US type is the main and most common type of babesiosis within the northeastern and midwestern regions of the USA [
16]. In the present studies, both patients visited babesiosis-endemic regions of the USA and reported clinical symptoms within babesiosis incubation time. In the second case, the identification of the
Babesia strain as the most often occurring strain in the USA was at a molecular level of evidence. This result aligns with the patient’s travel history to the endemic region and related clinical symptoms of babesiosis. These cases of travel-acquired human babesiosis diagnosed in the Republic of Korea highlight the crucial consideration required for returning travelers from babesiosis-endemic countries, such as the USA, and European countries. Additionally, diagnosis via PCR with sequence analysis is crucial for determining specific
Babesia species. These data are essential to comprehending the epidemiology and origin of pathogens.
Given the rising number of travelers returning from babesiosis-endemic countries, the risk of travel-acquired babesiosis is increasing. Although babesiosis was described as a notifiable disease by the Sentinel surveillance system in the Republic of Korea in 2011, awareness among physicians remains insufficient. As a result, some babesiosis descriptions, including molecular phylogeny and morphological analyses, are incomplete. Babesiosis diagnosis in non-endemic areas requires knowledge of the disease. Furthermore, surveillance of vectors having babesias, including ticks, and mammals, is required to understand changes in babesiosis distribution or the introduction of new Babesia spp. in naïve areas.
Notes
-
Author contributions
Conceptualization: Ju JW
Data curation: Kim HJ, Shin HI
Formal analysis: Kim HJ
Investigation: Kim MJ
Methodology: Kim HJ, Shin HI
Project administration: Lee HI
Supervision: Lee HI
Visualization: Kim HJ
Writing – original draft: Kim HJ, Kim MJ
Writing – review & editing: Shin HI, Ju JW, Lee HI
-
The authors declare no competing financial interest. Moreover, the datasets generated during and/or analyzed during the current study are available from the corresponding author upon reasonable request.
Acknowledgment
This research was supported by the Korea Disease Control and Prevention Agency (grant no. 6331-311-210).
Fig. 1Case 1: Wright–Giemsa-stained blood smear from the peripheral blood. Ring forms (A) and tetrad (Maltese cross) forms (B) of Babesia sp. are seen.

Fig. 2Case 2: Wright–Giemsa-stained blood smear from the peripheral blood the ring form of parasites.

Fig. 3Case 2: Phylogenetic tree of 18S rRNA gene sequences of Babesia microti US-type. The neighbor-joining approach was used to develop phylogenetic relationships using MEGA 6.0 software. The numbers on the nodes indicate the percentage of replicates of 1,000 samplings. The scale bar indicates 0.01 nucleotide substitutions per site. Babesia microti sequences obtained in this research are denoted by a solid square (■, GenBank accession no. MZ727029).

References
- 1. Yabsley MJ, Shock BC. Natural history of zoonotic babesia: role of wildlife reservoirs. Int J Parasitol Parasites Wildl 2013;2:18-31. https://doi.org/10.1016/J.IJPPAW.2012.11.003
- 2. Vannier E, Krause PJ. Update on babesiosis. Interdiscip Perspect Infect Dis 2009;2009:984568. https://doi.org/10.1155/2009/984568
- 3. Krause PJ. Human babesiosis. Int J Parasitol 2019;49(2):165-174. https://doi.org/10.1016/j.ijpara.2018.11.007
- 4. Krause PJ. Babesiosis diagnosis and treatment. Vector Borne Zoonotic Dis 2003;3(1):45-51. https://doi.org/10.1089/153036603765627451
- 5. Vannier E, Gewurz BE, Krause PJ. Human babesiosis. Infect Dis Clin North Am 2008;22(3):469-488. viii-ix. https://doi.org/10.1016/j.idc.2008.03.010
- 6. Kim HT, Song YW, Choe KW, Chai JY, Lee SH. An imported case of human babesiosis in Korea. Korean J Intern Med 1988;35(4):569-573. (in Korean)..
- 7. Kwon HY, Im JH, Park YK, Durey A, Lee JS, Baek JH. Two imported cases of babesiosis with complication or co-infection with lyme disease in Republic of Korea. Korean J Parasitol 2018;56(6):609-613. https://doi.org/10.3347/kjp.2018.56.6.609
- 8. Na YJ, Chai JY, Jung BK, Lee HJ, Song JY, et al. An imported case of severe falciparum malaria with prolonged hemolytic anemia clinically mimicking a Coinfection with babesiosis. Korean J Parasitol 2014;52(6):667-672. https://doi.org/10.3347/KJP.2014.52.6.667
- 9. Hong SH, Kim SY, Song BG, Rho JR, Cho CR, et al. Detection and characterization of an emerging type of Babesia sp. similar to Babesia motasi for the first case of human babesiosis and ticks in Korea. Emerg Microbes Infect 2019;8(1):869-878. https://doi.org/10.1080/22221751.2019.1622997
- 10. Kim JY, Cho SH, Joo HN, Tsuji M, Cho SR, et al. First case of human babesiosis in Korea: detection and characterization of a novel type of Babesia sp. (KO1) similar to ovine Babesia. J Clin Microbiol 2007;45(6):2084-2087. https://doi.org/10.1128/JCM.01334-06
- 11. Chen Z, Li H, Gao X, Bian A, Yan H, et al. Human babesiosis in China: a systematic review. Parasitol Res 2019;118:1103-1112. https://doi.org/10.1007/s00436-019-06250-9
- 12. Jalovecka M, Hajdusek O, Sojka D, Kopacek P, Malandrin L. The complexity of piroplasms life cycles. Front Cell Infect Microbiol 2018;8:248. https://doi.org/10.3389/fcimb.2018.00248
- 13. Laha R, Das M, Sen A. Morphology, epidemiology, and phylogeny of Babesia: An overview. Trop Parasitol 2015;5(2):94-100. https://doi.org/10.4103/2229-5070.162490
- 14. Homer MJ, Aguilar-Delfin I, Telford SR, Krause PJ, Persing DH. Babesiosis. Clin Microbiol Rev 2000;13(3):451-469. https://doi.org/10.1128/CMR.13.3.451
- 15. Goethert HK. What Babesia microti is now. Pathogens 2021;10(9):1168. https://doi.org/10.3390/PATHOGENS10091168
- 16. Nakajima R, Tsuji M, Oda K, Zamoto-Niikura A, Wei Q, et al. Babesia microti-group parasites compared phylogenetically by complete sequencing of the CCTη gene in 36 isolates. J Vet Med Sci 2009;71:55-68. https://doi.org/10.1292/jvms.71.55